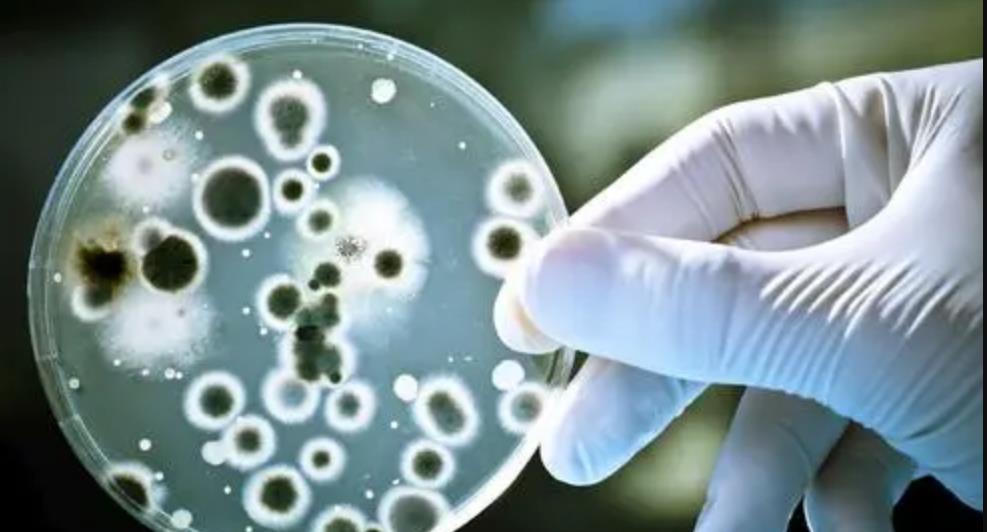
情微说 NASA要找回月球上的96袋纸尿裤？半世纪后，成“野生实验室”

情微说 NASA要找回月球上的96袋纸尿裤?半世纪后,成“野生实验室”

文章图片

文章图片

文章图片

文章图片

文章图片

文章图片
文章图片

文章图片

随着深空探索技术的不断发展 , 新一轮的月球探测竞赛已经开始 , 在我国相继把嫦娥系列送上月球之后 , 美国终于按捺不住宣布了重启探测月球的计划 , 这是自从1972年美国宣布终止阿波罗计划之后首次正式提出将重返月球 。
毕竟是现在全世界唯一一个实现过载人登月的国家 , 连返回月球的理由都更加奇葩 , NASA声称此次返回月球除了要在月球上实行“划地计划”以外 , 还要找回之前扔在月球上的96袋纸尿裤 , 他们认为这些纸尿裤当中的细菌可能依旧存活 , 取回他们有利于研究太空环境对细菌的影响 。
但是看到这一新闻的不少人认为 , 那些纸尿裤早都被宇宙辐射消解了 , 毕竟已经过去了半个世纪 。 也有人对于美国在月球上乱扔垃圾的行为表示谴责 , 但是显然美国人不以为然 , 他们认为这些纸尿裤已经成为了月球上的“野生实验室” 。 太空纸尿裤竟能变成实验室听起来就匪夷所思 , 不如来看看美国人的发言有没有夸张成分 , 纸尿裤都能被变废为宝 。
阿波罗登月遗留纸尿裤
阿波罗登月计划无疑是美国航天史上最伟大的计划之一 , 当时的美国为了展示本国雄厚的财力以及科研能力 , 在1961年时向全世界宣布实施载人登月计划 , 以太阳神的名字阿波罗命名 , 表示十年之内必将实现这一创举 。 整个计划从宣布到终止 , 大概经历了11年的时间 。 1969年7月20日 , 美国首次完成了登月 , 登月宇航员正是我们熟知的阿姆斯特朗和奥尔德林 。
首战告捷的美国在这之后加紧了发射计划 , 在阿波罗11号之后的三年期间 , 再次发射了6次飞船 , 有5次都发射成功 , 前后一共有12位宇航员登陆月球 。 其中阿波罗15号、16号、17号还携带着月球车登陆月球 , 宇航员驾驶月球车在月球上进行“兜风” , 巡游了不少地方 , 如月球上的山脉、峡谷等等 。
阿波罗计划的宇航员们一共在月球上停留了280小时左右 , 出舱活动的时间大概占到20% , 只有80小时左右 , 行动轨迹大概有100公里 。 这种不同于前期苏联和美国载人飞船升空 , 宇航员需要在月球上停留一天到两天以上 , 因此正常的生理排泄还是需要的 。
为了满足登月宇航员的生理需求 , 阿波罗十一号给每一位宇航员都配备了“太空纸尿裤” , 这样他们即使是在舱外进行勘察工作时有了尿意 , 也可以立即排泄 , 十分方便 。
经验总结扩展阅读
- 致我们人生中,那些说散就散的人
- 阿富汗与不同国家商业体系
- 生活听语兮:大声说爱你,喜欢就大胆说出来
- 真正的友情,从不喧哗
- 深圳宝山技工学校│有些事,说出来,那都不是事!
- 换一种思维,换一种人生
- 会偷三种懒,享尽一生福
- 有一种刻在骨子里的修养,叫不说
- 很多人都这样觉得 71岁大爷说“退休之后,一定要留钱养老
- 爱情 图钱和不图钱的女人,在男人心里是怎样的位置?两个男人说了实话
